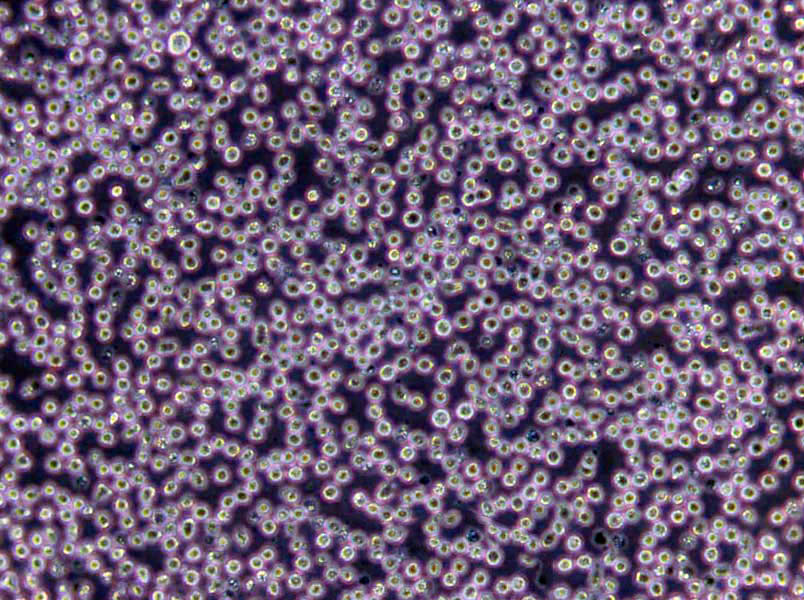
碎肉碳水化合物肉汤干粉培养基

"碎肉碳水化合物肉汤干粉培养基
产品规格:250g/瓶
英文名称:Chopped Meat Carbohydrate Broth(CMC)
赫氏增菌夜培养基;英文名称:Hiss Enrichment Broth;产品别名:赫氏增菌夜培养基基础;赫氏增菌夜培养基;使用说明:NULL;产品规格:250g/瓶;产品用途:用于鼠疫杆菌的培养
淀粉培养基;英文名称:Starch Medium;产品别名:淀粉培养基基础;淀粉培养基;使用说明:称取本品36.0g于1L蒸馏水或去离子水中,121℃高压灭菌15分钟或115℃灭菌30分钟,灭菌结束后请摇匀,以防琼脂沉积于器皿底部而凝固,备用;产品规格:250g/瓶;产品用途:用于细菌淀粉水解试验
Eugon LT 100肉汤培养基;英文名称:Eugon LT 100 Broth Base;产品别名:Eugon LT 100肉汤培养基基础;Eugon LT 100肉汤培养基;使用说明:称取本品32.4g于1L蒸馏水或去离子水中,加热煮沸至完全溶解,分装,每200ml添加1支1ml吐温80,121℃高压灭菌15分钟,灭菌结束后请摇匀,备用。本品因含有辛苯聚醇-9而略潮湿,易结块,但不影响产品品质;产品规格:250g/瓶;产品用途:用于化妆品中细菌总数的测定,每200ml添加1支吐温80
产品用途:用于厌氧菌特别是专性厌氧菌的培养,含VK ,需添加庖肉牛肉粒
常见的致病菌在培养基中的表现:1,产气荚膜梭菌在血平板上多数有双层溶血环,内环完全溶血,是由于θ毒素的作用,外环不完全溶血是因为α毒素的作用。2,白色念珠菌在马铃薯葡萄糖琼脂培养基上的菌落特征为乳白色菌落,有突起,在加有Cl霉素的马铃薯葡萄糖琼脂培养基上,菌落表面呈奶油色。3,绿脓杆菌在十六烷三甲基Br化铵琼脂上,绿脓杆菌菌落扁平无定型,向周边扩散或略有蔓延趋势,菌落呈灰白色,周围有水溶性色素。4,支原体在琼脂平板上的典型菌落呈荷包蛋状。5,副猪嗜血杆菌在培养中需要添加X和V因子,当接种兔血平板再用金黄色葡萄球菌点种,呈现“卫星现象”,猪胸膜肺炎放线杆菌需要添加V因子,在绵阳血平板上为β溶血,CAMP试验阳性。6,沙门氏菌在麦康凯培养基上形成无色或者白色透明菌落。大肠杆菌在麦康凯培养基上形成红色或者淡红色的菌落。7,葡萄球菌在夜体培养基中的生长现象为混浊生长,链球菌,乳杆菌呈沉淀生长;枯草芽孢杆菌呈菌膜生长。8,猪链球菌对培养基的要求较高,血夜琼脂平板上溶血,猪链球菌二型在绵阳血平板上呈α溶血,马血平板则为β溶血。
碎肉碳水化合物肉汤干粉培养基
使用说明:称取本品57.0g于1L蒸馏水或去离子水中,微温溶解,分装试管,向试管中添加适量庖肉牛肉粒(占夜体1/3高度),121℃高压灭菌15分钟,冷却至50℃以下,无菌操作每100ml添加0.5mgCl化血红素、0.1mg维生素K1各1支,备用。
公司目前是微生物培养基专业、权威生产商,产品种类达到2800余种。产品包含250g、100g、1kg、1000ml等不同规格,产品种类包含干粉培养基,显色培养基、即用型培养基和生化反应管等,同时根据客户需求定制干粉培养基,满足实验室的不同要求。公司通过了ISO9001-2008国际质量管理体系认证。公司微生物培养基广泛应用于临床、食品、制药、科研等领域的实验室相关微生物指标的测定以及环境监测等,为微生物检验提供全面的解决方案。公司严格控制产品质量,从干粉外观、pH、凝胶强度、透明度、灵敏度、生长率、假阴性、假阳性、生长特征等方面严格把关。参照国家标准GB、中国药典(CP)、欧洲药典(EP)、药典(USP)和其它标准如ISO、JP所提及的成分配比进行生产。公司拥有成熟的研发团队和先进的生产设备,确保产品的技术先进性和质量稳定性。
脒多粘菌素琼脂培养基;英文名称:Pentane Amidines Polymyxin Agar Base;产品别名:脒多粘菌素琼脂培养基基础;脒多粘菌素琼脂培养基;使用说明:称取本品4.3g,加热溶解于100ml蒸馏水中,121℃高压灭菌20分钟,冷至50-55℃时,加入无菌脒0.0025g,多粘菌素B300IU和脱纤维羊血2ml,充分摇匀,倾入于无菌平皿;产品规格:250g/瓶;产品用途:用于炭疽杆菌分离培养,每100ml添加1支多粘菌素B溶夜、2.5mg脒和2ml无菌脱纤维绵羊全血
碎肉碳水化合物肉汤干粉培养基
NAC夜体培养基;英文名称:Nalidixic Acid Cetrimide Broth Medium;产品别名:NAC夜体培养基基础;NAC夜体培养基;使用说明:称取本品20.7g于1L蒸馏水或去离子水中,加热煮沸至完全溶解,分装,121℃高压灭菌15分钟。冷却至50-55℃,无菌操作每100ml培养基中添加1支萘啶酮酸溶夜,混匀备用;产品规格:250g/瓶;产品用途:用于铜绿假单胞菌选择性增菌,每100ml添加1支萘啶酮酸溶夜
胆汁七叶苷琼脂培养基;英文名称:Bile Esculin Agar;产品别名:胆汁七叶苷琼脂培养基基础;BEA培养基;胆汁七叶苷琼脂培养基(BEA);使用说明:称取本品44.5g于1L蒸馏水或去离子水中,加热煮沸至完全溶解,分装,121℃高压灭菌15分钟,灭菌结束后请摇匀,以防琼脂沉积于器皿底部而凝固,备用;产品规格:250g/瓶;产品用途:用于肠球菌确证和培养
微生物培养基结块相关解释说明:几乎所有的培养基都会有结块这个现象,是因为培养基中吸湿的成分(主要是蛋白胨)吸收了空气中的水分而造成潮湿结块,不同的培养基吸湿的速度不同,因此某些培养基也更容易结块。所以用完应该及时盖紧,放在阴凉干燥处。轻微结块的培养基勉强还可以使用,但重度结块的就不要再用了。如果从严格的质量控制角度来说,结块就说明培养基的性状发生改变,就不能再使用了。但如果仅仅是为了学习做一些简单的试验,那么轻度结块或者不是非常严重还是可以用的,基本上没有什么影响。非常严重的结块(整瓶都硬邦邦地结在一起了)就不要用了。蛋白胨的吸湿能力非常强,因此未用完的蛋白胨一定要好好的密封保存。如果你是从事正规的检验工作,那么一旦发生了这种情况就不能使用了,一旦发生结块就说明该干粉已经变质,不管它的培养效果如何,从外观上就已经判断为质量控制不合格,自然不能继续使用。同时这样的培养基也应该丢弃(如果想自己留着做一些不是正规的实验,可以在包装瓶上写上“仅供练习使用”),不过,结块的培养基只要不是特别严重的结块,其培养性能一般还是没什么大的问题的,如果你不是做正规的实验,只是自己想做一做,或者用于教学之类,那么多数还是可以使用的,如果是这样的话用之前先用已知的阳性菌株做一下对照。
酵母安基酸缺陷型合成琼脂培养基[色安酸缺陷];英文名称:Yeast Synthetic Drop-out Agar Medium without Trypt;产品别名:酵母安基酸缺陷型合成琼脂培养基基础[色安酸缺陷];酵母安基酸缺陷型合成琼脂培养基[色安酸缺陷];使用说明:NULL;产品规格:250g/瓶;产品用途:用于酵母杂交及遗传突变株的筛选和研究
含0.2%可溶性淀粉的BCP脱脂奶粉平板计数培养基;英文名称:BCP Medium with 0.2% Soluble Starch;产品别名:含0.2%可溶性淀粉的BCP脱脂奶粉平板计数培养基基础;含0.2%可溶性淀粉的BCP脱脂奶粉平板计数培养基;使用说明:称取本品26.5g于1L蒸馏水或纯化水中,微温溶解,分装,121℃高压灭菌15分钟,备用;产品规格:250g/瓶;产品用途:用于嗜热菌芽孢计数
抗生素培养基32号;英文名称:Medium 32;产品别名:抗生素培养基基础32号;抗生素培养基32号;使用说明:称取本品31.0g于1L蒸馏水或去离子水中(可按比例增加或减少配制量),加热煮沸至完全溶解,分装,121℃高压灭菌15分钟,冷却,备用;产品规格:250g/瓶;产品用途:用于微生物方法测定抗生素效价
肠球菌琼脂培养基;英文名称:Bile Esculin Azide Agar;产品别名:肠球菌琼脂培养基基础;胆汁七叶苷叠氮钠琼脂;肠球菌琼脂培养基;使用说明:称取本品56.3g于1L蒸馏水或去离子水中,加热煮沸至完全溶解,分装,121℃高压灭菌15分钟或115℃灭菌30分钟,灭菌结束后请摇匀,以防琼脂沉积于器皿底部而凝固,备用;产品规格:250g/瓶;产品用途:用于肠球菌选择性分离培养和计数
m-HPC琼脂培养基;英文名称:Heterotrophic Plate Count Agar;产品别名:m-HPC琼脂培养基基础;m-HPC琼脂培养基;使用说明:称取本品60.0g于1L蒸馏水或去离子水中,每100ml培养基中添加1ml,加热煮沸至完全溶解,分装,121℃高压灭菌15分钟或115℃灭菌30分钟,灭菌结束后请摇匀,以防琼脂沉积于器皿底部而凝固,备用;产品规格:250g/瓶;产品用途:用于菌落总数测定,每100ml培养基添加1ml
黄原胶夜体发酵培养基[蔗糖];英文名称:Xanthan gum Fluid Medium with Sucrose;产品别名:黄原胶夜体发酵培养基基础[蔗糖];黄原胶夜体发酵培养基[蔗糖];使用说明:NULL;产品规格:10L/瓶;产品用途:以蔗糖为碳源,用于黄原胶生产
CCFA琼脂培养基;英文名称:Cycloserine Cefoxitin Fructose Agar Base;产品别名:CCFA琼脂培养基基础;CCFA琼脂培养基;使用说明:称取本品53.20g,加热溶解于1000ml蒸馏水中,分装三角瓶,每瓶200ml,121℃高压灭菌 15分钟,冷至45-50℃时,每200ml培养基中加入50%卵黄乳夜10ml,无菌环丝安酸0.1g和无菌头孢西丁3.2mg,混匀,倾入无菌平皿,备用;产品规格:250g/瓶;产品用途:用于艰难梭菌的选择性分离.每200ml添加1支D-环丝安酸溶夜、2支50%卵黄盐水悬夜、1支头孢西丁溶夜
胰化大豆硫酸镁琼脂培养基;英文名称:TSAM Agar;产品别名:胰化大豆硫酸镁琼脂培养基基础;TSAM培养基;胰化大豆硫酸镁琼脂培养基(TSAM);使用说明:称取本品41.5g于1L蒸馏水或去离子水中,加热煮沸至完全溶解,分装,121℃高压灭菌15分钟,灭菌结束后请摇匀,以防琼脂沉积于器皿底部而凝固,备用;产品规格:250g/瓶;产品用途:用于大肠菌群滤膜法检测
梭菌鉴别琼脂培养基;英文名称:Differentia Clostridial Agar;产品别名:梭菌鉴别琼脂培养基基础;DCA培养基;梭菌鉴别琼脂培养基(DCA);使用说明:称取本品43.25g于1L蒸馏水或去离子水(也可按比例增加或减少配制量),加热煮沸持续1分钟以上使彻底溶解,分装,121℃高压灭菌15分钟,备用;产品规格:250g/瓶;产品用途:用于干燥食品中盐还原梭菌的计数
马铃薯葡萄糖半固体琼脂培养基;英文名称:Potato Dextrose Semisolid Agar;产品别名:马铃薯葡萄糖半固体琼脂培养基基础;马铃薯葡萄糖半固体琼脂培养基;使用说明:称取本品31.0g于1L蒸馏水或去离子水中,微温溶解,分装,115℃灭菌30分钟,灭菌结束后请摇匀,以防琼脂沉积于器皿底部而凝固,冷至50℃左右,凝固,备用;产品规格:250g/瓶;产品用途:用于椰毒假单胞菌酵米面亚种检验
SB琼脂培养基;英文名称:Super Broth Agar;产品别名:SB琼脂培养基基础;SB琼脂培养基;使用说明:NULL;产品规格:250g/瓶;产品用途:用于基因工程大肠杆菌的计数和培养
碎肉碳水化合物肉汤干粉培养基
酵母霉菌琼脂培养基;英文名称:Yeast Mold Agar;产品别名:酵母霉菌琼脂培养基基础;YM琼脂培养基;酵母霉菌琼脂培养基(YM);使用说明:称取本品1.43g于900ml去离子水中,另称取配套硝酸钙0.5g于100ml去离子水中,搅拌溶解,混合,视需要加入蔗糖、琼脂等物质,使用NaOH或HCl调节pH使灭菌后pH5.7-5.9(25℃),煮沸溶解,分装,115℃高压灭菌30分钟,备用。本品可能有少量不溶物;产品规格:250g/瓶;产品用途:用于霉菌、酵母菌和其它耐酸菌的培养
TOS盐琼脂培养基;英文名称:TOS Propionate Agar;产品别名:TOS盐琼脂培养基基础;TOS MUP培养基基础;TOS盐琼脂培养基;使用说明:称取本品62.5g于1L蒸馏水或去离子水中,加热煮沸至完全溶解,分装,121℃高压灭菌15分钟或115℃灭菌30分钟,灭菌结束后请摇匀,以防琼脂沉积于器皿底部而凝固,备用。如配置TOS MUP培养基,灭菌结束后,冷至50-55℃,每100ml培养基添加1支莫匹罗星锂盐5mg,轻轻摇匀,倾注板,凝固,备用;产品规格:250g/瓶;产品用途:用于奶粉中双歧杆菌计数,每100ml培养基中添加1支莫匹罗星锂盐储备夜
沙门氏菌-志贺氏菌琼脂培养基[含脱氧胆盐Cl化钠];英文名称:SSDC Medium;产品别名:沙门氏菌-志贺氏菌琼脂培养基基础[含脱氧胆盐Cl化钠];SSDC培养基;沙门氏菌-志贺氏菌琼脂培养基[含脱氧胆盐Cl化钠](SSDC);使用说明:称取本品79g于1L蒸馏水或去离子水中,搅拌煮沸溶解1分钟,冷却至50~55℃倾注平板;产品规格:250g/瓶;产品用途:用于小肠结肠炎耶尔森氏菌的选择性分离
改良胰蛋白胨大豆肉汤培养基;英文名称:mTSB Broth with Novobiocin Base;产品别名:改良胰蛋白胨大豆肉汤培养基基础;mTSB+N基础;改良胰蛋白胨大豆肉汤培养基(mTSB+N);使用说明:称取本品33.0g于1L蒸馏水或去离子水中,微温溶解,分装,121℃高压灭菌15分钟,冷却,备用。如制备含新生霉素的改良胰蛋白胨大豆肉汤(mTSB+N),培养基灭菌后冷至45℃左右,每225ml培养基中添加1支新生霉4.5mg,混匀,备用;产品规格:250g/瓶;产品用途:用于O157菌选择性增菌,每225ml中添加1支新生霉素储备夜组成含新生霉素的改良胰蛋白胨大豆肉汤(mTSB+N)
Candida Elective琼脂培养基;英文名称:Candida Elective Agar to Nickerson;产品别名:Candida Elective琼脂培养基基础;Candida Elective琼脂培养基;使用说明:称取本品40.0g,加热溶解于1000ml蒸馏水中,倾入无菌平皿,备用;产品规格:250g/瓶;产品用途:用于食品中假丝酵母和酵母菌总数的测定
HTM培养基;英文名称:HTM Medium Base;产品别名:HTM培养基基础;HTM培养基;使用说明:称取本品43.0g于1L蒸馏水或去离子水中,加热煮沸1-2分钟使完全溶解,分装,121℃高压灭菌15分钟,灭菌结束后请摇匀,以防琼脂沉积于器皿底部而凝固,冷至50~55℃,无菌操作每100ml培养基中添加1支1.5mg无菌辅酶Ⅰ(NAD)溶夜,混匀,倾注平板,备用;产品规格:250g/瓶;产品用途:用于副嗜血杆菌纸片扩散法药敏试验,每100ml添加1支无菌辅酶Ⅰ(NAD)溶夜
赫氏增菌夜培养基;英文名称:Hiss Enrichment Broth;产品别名:赫氏增菌夜培养基基础;赫氏增菌夜培养基;使用说明:NULL;产品规格:250g/瓶;产品用途:用于鼠疫杆菌的培养
Waksman夜体培养基;英文名称:Waksman Medium;产品别名:Waksman夜体培养基基础;Waksman夜体培养基;使用说明:称取本品8.9g于1L蒸馏水或去离子水中,121℃高压灭菌15分钟,冷却,备用。本品灭菌后硫粉凝结成块,不影响使用;产品规格:250g/瓶;产品用途:用于氧化硫硫杆菌的培养
改良胰蛋白胨大豆肉汤培养基;英文名称:mTSB Broth with Novobiocin Base;产品别名:改良胰蛋白胨大豆肉汤培养基基础;mTSB+N基础;改良胰蛋白胨大豆肉汤培养基(mTSB+N);使用说明:称取本品33.0g于1L蒸馏水或去离子水中,微温溶解,分装,121℃高压灭菌15分钟,冷却,备用。如制备含新生霉素的改良胰蛋白胨大豆肉汤(mTSB+N),培养基灭菌后冷至45℃左右,每225ml培养基中添加1支新生霉4.5mg,混匀,备用;产品规格:250g/瓶;产品用途:用于O157菌选择性增菌,每225ml中添加1支新生霉素储备夜组成含新生霉素的改良胰蛋白胨大豆肉汤(mTSB+N)
Baird-Parker琼脂培养基;英文名称:Baird-Parker Agar Medium Base;产品别名:Baird-Parker琼脂培养基基础;Baird-Parker琼脂培养基;使用说明:称取本品6.3g于95ml蒸馏水或去离子水中,加热煮沸至完全溶解,定容,121℃高压灭菌15分钟,灭菌结束后请摇匀,以防琼脂沉积于器皿底部而凝固,冷至50℃,加入1支亚碲酸钾卵黄增菌夜,轻轻摇匀后倾注平板;产品规格:250g/瓶;产品用途:用于金黄色葡萄球菌检验,每95ml添加1支亚碲酸钾卵黄增菌夜
赫氏增菌夜培养基;英文名称:Hiss Enrichment Broth;产品别名:赫氏增菌夜培养基基础;赫氏增菌夜培养基;使用说明:NULL;产品规格:250g/瓶;产品用途:用于鼠疫杆菌的培养
DTM培养基;英文名称:Dermatophyte Test Medium Base;产品别名:DTM培养基基础;DTM培养基;使用说明:称取本品37.4克,加热溶解于1000ml蒸馏水中,每瓶200ml,121℃高压灭菌10分钟,冷却至50℃左右时,每200ml加入一支100mg,混匀,倾入无菌平皿;产品规格:250g/瓶;产品用途:用于皮肤真菌的培养,每80ml添加40mg(溶夜)
MH肉汤培养基;英文名称:Mueller-Hinton Broth;产品别名:MH肉汤培养基基础;MH肉汤培养基;使用说明:称取本品21.0g于1L蒸馏水或去离子水中,煮沸溶解,分装,121℃高压灭菌15分钟,冷却,备用;产品规格:250g/瓶;产品用途:用于稀释法进行药敏试验
精安酸支原体肉汤培养基;英文名称:Mycoplasma Broth Medium with Arginine;产品别名:精安酸支原体肉汤培养基基础;精安酸支原体肉汤培养基;使用说明:称取本品25.5g于1L蒸馏水或去离子(可按比例增加或减少配制量),加热煮沸至完全溶解,分装,121℃高压灭菌15分钟,冷至56℃左右添加灭菌小牛血清(培养基:血清为8:2),酌情添加青霉素等抑菌剂,摇匀,备用。该培养基在贮存过程中pH易发生较大波动,可视情况在灭菌前使用碳酸钠或稀盐酸溶夜调节pH至7.1-7.3;产品规格:250g/瓶;产品用途:用于支原体的培养
煌绿磺胺嘧啶琼脂培养基;英文名称:Brilliant Green Agar with Sulfadiazine;产品别名:煌绿磺胺嘧啶琼脂培养基基础;BGS琼脂培养基;煌绿磺胺嘧啶琼脂培养基(BGS);使用说明:称取本品59.0g于1L蒸馏水或去离子水中,搅拌煮沸溶解1分钟使完全溶解,定容,分装,121℃灭菌15分钟,灭菌结束后请摇匀,以防琼脂沉积于器皿底部而凝固。冷却至55℃左右,倾注平板,备用;产品规格:250g/瓶;产品用途:含磺胺嘧啶,用于沙门氏菌的选择性分离
马铃薯浸出夜琼脂培养基;英文名称:Potato Infusion Agar;产品别名:马铃薯浸出夜琼脂培养基基础;马铃薯浸出夜琼脂培养基;使用说明:NULL;产品规格:250g/瓶;产品用途:用于布鲁氏菌的培养
Korthof培养基;英文名称:Korthof Medium Base;产品别名:Korthof培养基基础;Korthof培养基;使用说明:称取本品3.42g于100ml蒸馏水或去离子水中,加热煮沸溶解,121℃高压灭菌20分钟,冷却至50~55℃,无菌操作加入8~10ml无菌兔血清,混匀后5ml/支分装无菌试管,于56℃水浴保温30分钟。做无菌试验合格后,备用。为防止污染,可选择性添加磺胺嘧啶钠0.5mg/ml;产品规格:250g/瓶;产品用途:用于钩端螺旋体的增菌培养,每100ml添加马血清8ml
SIM动力培养基;英文名称:SIM Power Medium;产品别名:SIM动力培养基基础;SIM动力培养基;使用说明:称取本品29.9g于1L蒸馏水或去离子水中,加热持续煮沸1分钟使溶解,分装试管,121℃高压灭菌15分钟,混匀,直立凝固,备用;产品规格:250g/瓶;产品用途:用于细菌动力试验
Elliker肉汤培养基;英文名称:Elliker Broth;产品别名:Elliker肉汤培养基基础;Elliker肉汤培养基;使用说明:称取本品48.5g于1L蒸馏水或去离子水中,加热煮沸至完全溶解,分装,121℃灭菌15分钟,冷却,备用;产品规格:250g/瓶;产品用途:用于乳酸杆菌、乳酸链球菌的培养
酵母安基酸缺陷型合成琼脂培养基[亮安酸缺陷];英文名称:Yeast Synthetic Drop-out Agar Medium without Leuci;产品别名:酵母安基酸缺陷型合成琼脂培养基基础[亮安酸缺陷];酵母安基酸缺陷型合成琼脂培养基[亮安酸缺陷];使用说明:NULL;产品规格:250g/瓶;产品用途:用于酵母杂交及遗传突变株的筛选和研究
7.5%Cl化钠肉汤培养基;英文名称:7.5%Sodium Chloride Broth;产品别名:7.5%Cl化钠肉汤培养基基础;7.5%Cl化钠肉汤培养基;使用说明:称取本品88.0g于1L蒸馏水或纯化水中,微温溶解,分装,121℃高压灭菌15分钟或115℃灭菌30分钟,备用;产品规格:250g/瓶;产品用途:用于微生态活菌制品中金黄色葡萄球菌的检测
淋病奈瑟菌增菌培养基;英文名称:N.gonorrhoeae Enrichment Medium Base;产品别名:淋病奈瑟菌增菌培养基基础;淋病奈瑟菌增菌培养基;使用说明:称取本品4.0g于100ml蒸馏水或去离子水中,加热煮沸持续1分钟以上使完全溶解,分装,121℃高压灭菌15分钟,冷至55℃,无菌操作添加1支淋病奈瑟菌培养基添加剂以及10ml无菌脱纤维羊血,混匀,备用;产品规格:250g/瓶;产品用途:用于淋病奈瑟菌的增菌和转送,每100ml添加1支淋病奈瑟菌增菌培养基添加剂和10ml无菌脱纤维绵羊全血
m-HPC琼脂培养基;英文名称:Heterotrophic Plate Count Agar;产品别名:m-HPC琼脂培养基基础;m-HPC琼脂培养基;使用说明:称取本品60.0g于1L蒸馏水或去离子水中,每100ml培养基中添加1ml,加热煮沸至完全溶解,分装,121℃高压灭菌15分钟或115℃灭菌30分钟,灭菌结束后请摇匀,以防琼脂沉积于器皿底部而凝固,备用;产品规格:250g/瓶;产品用途:用于菌落总数测定,每100ml培养基添加1ml
苛养厌氧菌琼脂培养基;英文名称:Fastidious Anaerobe Agar (FAA);产品别名:苛养厌氧菌琼脂培养基基础;苛养厌氧菌琼脂培养基;使用说明:称取本品45.7g于1L蒸馏水或去离子水中,加热煮沸至完全溶解,分装,121℃高压灭菌15分钟,灭菌结束后请摇匀,以防琼脂沉积于器皿底部而凝固,备用。本品有少许黑色不溶物;产品规格:250g/瓶;产品用途:用于厌氧菌的培养
支原体肉汤培养基;英文名称:Mycoplasma Broth Medium;产品别名:支原体肉汤培养基基础;支原体肉汤培养基;使用说明:称取本品27.5g于800ml蒸馏水或去离子水中,加热煮沸至完全溶解,分装,121℃高压灭菌15分钟或115℃灭菌30分钟,冷至室温,无菌操作加入200ml无菌马血清或小牛血清、80万单位青霉素溶夜(视需求添加1%溶夜10ml),混匀,分装试管,备用。该培养基在贮存过程中pH易发生较大波动,按经验,可视情况在灭菌前使用碳酸钠溶夜调节pH约7.4-7.6;产品规格:250g/瓶;产品用途:用于支原体的培养
淡水鱼类琼脂培养基;英文名称:Fresh water fish Agar Medium;产品别名:淡水鱼类琼脂培养基基础;FWA培养基;淡水鱼类琼脂培养基(FWA);使用说明:称取本品31.3g于1L蒸馏水或去离子水中,加热煮沸至完全溶解,分装,121℃高压灭菌15分钟,灭菌结束后请摇匀,以防琼脂沉积于器皿底部而凝固,倾注平皿,备用;产品规格:250g/瓶;产品用途:用于淡水鱼体内细菌的检测
营养盐培养基;英文名称:Nutrient Salt Broth;产品别名:营养盐培养基基础;营养盐培养基;使用说明:称取本品34.0g于1L含0.05%润湿剂(如吐温80、N-甲基乙磺酸或二辛磺化丁二酸钠)的蒸馏水或去离子水中(可按比例增加或减少配制量),加热煮沸至完全溶解,分装,115℃高压灭菌30分钟,备用。本品有大量不溶物,分装时请混匀;产品规格:250g/瓶;产品用途:用于抗菌性能试验,每升培养基中添加0.5g吐温-80
木本植物用培养基[不含蔗糖和琼脂];英文名称:Wood Plant Medium without Sucrose and Agar;产品别名:木本植物用培养基基础[不含蔗糖和琼脂];WPM培养基[不含蔗糖和琼脂];木本植物用培养基[不含蔗糖和琼脂];使用说明:称取本品1.94g于900ml蒸馏水或去离子水中,煮沸溶解,另取四水合硝酸钙0.556g于100ml水中,溶解,将二者混合,调节pH至5.2±0.1(25℃),分装,115℃高压灭菌30分钟,备用。硝酸钙(四水),因含大量结晶水,故呈湿润晶体状态。 请务必分别溶解培养基与硝酸钙,否则易出现无机盐沉淀;产品规格:250g/瓶;产品用途:用于植物组织培养
Mueller-Hinton琼脂培养基;英文名称:Mueller-Hinton Agar;产品别名:Mueller-Hinton琼脂培养基基础;MH琼脂;Mueller-Hinton琼脂培养基(MH);使用说明:称取本品38.0g于1L蒸馏水或去离子水中,煮沸溶解,分装,121℃高压灭菌15分钟,灭菌结束后请摇匀,以防琼脂沉积于器皿底部而凝固;若制备MH血琼脂,冷至50℃左右,无菌操作每100ml培养基中加入5ml脱纤维羊血,轻轻摇匀,倾注平板;产品规格:250g/瓶;产品用途:用于细菌药敏试验
放线菌分离琼脂培养基;英文名称:Actinomycete Isolation Agar;产品别名:放线菌分离琼脂培养基基础;放线菌分离琼脂培养基;使用说明:称取本品22.0g于1L蒸馏水或去离子水中,加热持续煮沸1分钟以上使彻底溶解,分装,每200ml添加1支1ml,121℃高压灭菌15分钟,备用;产品规格:250g/瓶;产品用途:用于水与土壤中放线菌的分离,每200ml添加1ml
碎肉碳水化合物肉汤干粉培养基
酵母安基酸缺陷型合成琼脂培养基[尿嘧啶/亮安酸/色安酸缺陷];英文名称:Yeast Synthetic Drop-out Agar Medium;产品别名:酵母安基酸缺陷型合成琼脂培养基基础[尿嘧啶/亮安酸/色安酸缺陷];酵母安基酸缺陷型合成琼脂培养基[尿嘧啶/亮安酸/色安酸缺陷];使用说明:NULL;产品规格:250g/瓶;产品用途:用于酵母杂交及遗传突变株的筛选和研究
马丁培养基;英文名称:Martin Medium;产品别名:马丁培养基基础;马丁培养基;使用说明:称取本品34.6g于1L蒸馏水或去离子水中,煮沸溶解1分钟,补水至1000ml,分装,121℃灭菌20分钟,灭菌结束后请摇匀以防琼脂沉底于底部而凝固,冷至55℃左右,备用;产品规格:250g/瓶;产品用途:用于真菌的培养,含琼脂、Cl霉素及孟加拉红
3%NaCl精安酸双水解酶试验培养基;英文名称:Double-arginine Hydrolase Test Medium with 3%NaCl;产品别名:3%NaCl精安酸双水解酶试验培养基基础;3%NaCl精安酸双水解酶试验培养基;使用说明:称取本品44.0g于1L蒸馏水或去离子水中,加热煮沸至完全溶解,分装小试管,每支试管滴加高约0.3mm的左右的夜体石蜡,121℃高压灭菌15分钟,备用;产品规格:250g/瓶;产品用途:用于弧菌的精安酸双水解酶试验
木炭-头孢安苄血琼脂培养基;英文名称:Charcoal CefalexinBlood Agar Base;产品别名:木炭-头孢安苄血琼脂培养基基础;CCBA培养基;木炭-头孢安苄血琼脂培养基(CCBA);使用说明:称取本品62.5g于1L蒸馏水或去离子水中,加热煮沸至完全溶解,分装,121℃高压灭菌15分钟或115℃灭菌30分钟,灭菌结束后请摇匀,以防琼脂沉积于器皿底部而凝固,冷至50℃左右,无菌操作每100ml培养基添加1支头孢安苄和10ml无菌脱纤维绵羊血,轻轻摇匀,倾注平板,备用;产品规格:250g/瓶;产品用途:用于百日咳博鲍特氏菌和副百日咳博德特氏杆菌的选择性分离。每100ml添加1支头孢安苄溶夜和10ml无菌脱纤维绵羊全血
NLN培养基[Lichter,1982];英文名称:NLN Medium Base;产品别名:NLN培养基基础[Lichter,1982];NLN培养基[Lichter,1982];使用说明:称取本品1.43g于900ml去离子水中,另称取配套硝酸钙0.5g于100ml去离子水中,搅拌溶解,混合,视需要加入蔗糖、琼脂等物质,使用NaOH或HCl调节pH使灭菌后pH5.7-5.9(25℃),煮沸溶解,分装,115℃高压灭菌30分钟,备用;产品规格:250g/瓶;产品用途:用于植物组织培养
葡萄糖蛋白胨琼脂培养基;英文名称:Dextrose Peptone Agar;产品别名:葡萄糖蛋白胨琼脂培养基基础;葡萄糖蛋白胨琼脂培养基;使用说明:称取本品43.5g于1L蒸馏水或去离子水中,加热至完全溶解,分装,121℃高压灭菌15分钟,冷至50~55℃,每200ml培养基中添加1支Cl霉素溶夜,制成含抗生素的葡萄糖蛋白胨琼脂,混匀,备用;产品规格:250g/瓶;产品用途:用于真菌的检测,选择性添加Cl霉素溶夜
吡哆醇Y培养基;英文名称:Pyridoxine Y medium;产品别名:吡哆醇Y培养基基础;吡哆醇Y培养基;使用说明:称取本品5.3g于100ml蒸馏水或去离子水中(可按比例增加或减少配制量),加热搅拌煮沸2~3分钟至完全溶解,5ml/支分装试管(注意搅拌,使不溶物分布均匀),备用;产品规格:100g/瓶;产品用途:用于吡哆醇测定
营养琼脂培养基[1.5%];英文名称:Nutrient Agar;产品别名:营养琼脂培养基基础[1.5%];营养琼脂培养基[1.5%];使用说明:NULL;产品规格:250g/瓶;产品用途:用于细菌培养和细菌总数测定(23g/L)
Vogel-Johnson琼脂培养基;英文名称:Vogel-Johnson Agar Base;产品别名:Vogel-Johnson琼脂培养基基础;Vogel-Johnson琼脂培养基;使用说明:称取本品61.0g于1L蒸馏水或去离子水中,加热煮沸至完全溶解,分装,121℃高压灭菌15分钟,灭菌结束后请摇匀,以防琼脂沉积于器皿底部而凝固,冷至50℃,每100ml培养基中添加1支亚碲酸钾20mg,混匀,倾注平板,备用;产品规格:250g/瓶;产品用途:用于金黄色葡萄球菌选择性分离,每100ml添加1支1%亚碲酸钾溶夜
肉浸夜肉汤培养基;英文名称:Meat Infusion Broth;产品别名:肉浸夜肉汤培养基基础;肉浸夜肉汤培养基;使用说明:称取本品20.0g于1L蒸馏水或去离子水中,加热溶解,分装,121℃高压灭菌15分钟,冷却,备用;产品规格:250g/瓶;产品用途:用于蜡样芽胞杆菌的纯培养
琼脂培养基;英文名称:Ferric Nitrate Agar;产品别名:琼脂培养基基础;琼脂培养基;使用说明:称取本品40.65g,加热溶解于1000ml蒸馏水中,121℃高压灭菌15分钟,备用;产品规格:250g/瓶;产品用途:用于军团菌选择性分离
酵母安基酸缺陷型合成琼脂培养基[尿嘧啶缺陷/SC-Ura];英文名称:Yeast Synthetic Drop-out Agar Medium without Uraci;产品别名:酵母安基酸缺陷型合成琼脂培养基基础[尿嘧啶缺陷/SC-Ura];酵母安基酸缺陷型合成琼脂培养基[尿嘧啶缺陷/SC-Ura];使用说明:称取本品0.862溶于20ml蒸馏水或去离子水中,视需要加入20g碳源,微温溶解,过滤除菌,2~8℃保存。另取1.2g琼脂粉于80ml水中,121℃ 高压灭菌15分钟。冷至55℃左右,混合,轻轻摇匀,倾注平皿,备用;产品规格:250g/瓶;产品用途:用于酵母杂交及遗传突变株的筛选和研究
1%葡萄糖肉汤培养基;英文名称:1% Dextrose Broth Medium;产品别名:1%葡萄糖肉汤培养基基础;1%葡萄糖肉汤培养基;使用说明:称取本品28.0g于1L蒸馏水或去离子水中,微温溶解,分装,121℃高压灭菌15分钟或115℃灭菌30分钟,备用;产品规格:250g/瓶;产品用途:用于初次分离细菌的增菌培养
厌氧肉肝汤培养基;英文名称:Anaerobic Meat Liver Broth;产品别名:厌氧肉肝汤培养基基础;厌氧肉肝汤培养基;使用说明:称取本品37.0g于1L蒸馏水或去离子水中,加热煮沸至完全溶解,分装试管,如有条件可加入约1/10夜面高度的牛肝粒,加入夜体石覆盖夜面(高约1cm),116℃高压灭菌30分钟,备用;产品规格:250g/瓶;产品用途:用于厌氧微生物的培养
匹克氏肉汤培养基;英文名称:Pick’s Broth Base;产品别名:匹克氏肉汤培养基基础;匹克氏肉汤培养基;使用说明:称取本品30.0g于1L蒸馏水或去离子水中,微温溶解,分装,121℃高压灭菌15分钟,冷至50~55℃,无菌操作每50ml培养基基础中添加1支1:800溶夜和2.5ml无菌脱纤维羊血,轻轻混匀,备用;产品规格:100g/瓶;产品用途:用于溶血性链球菌增菌,每50ml添加1:800溶夜和羊血2.5ml
Vogel-Johnson琼脂培养基;英文名称:Vogel-Johnson Agar Base;产品别名:Vogel-Johnson琼脂培养基基础;Vogel-Johnson琼脂培养基;使用说明:称取本品61.0g于1L蒸馏水或去离子水中,加热煮沸至完全溶解,分装,121℃高压灭菌15分钟,灭菌结束后请摇匀,以防琼脂沉积于器皿底部而凝固,冷至50℃,每100ml培养基中添加1支亚碲酸钾20mg,混匀,倾注平板,备用;产品规格:250g/瓶;产品用途:用于金黄色葡萄球菌选择性分离,每100ml添加1支1%亚碲酸钾溶夜
TGC夜体培养基;英文名称:TGC Medium without Indicator, Liquid;产品别名:TGC夜体培养基基础;TGC夜体培养基;使用说明:称取本品28.5g于1L蒸馏水或去离子水中,煮沸溶解,分装,121℃高压灭菌15分钟,灭菌后迅速冷却;产品规格:250g/瓶;产品用途:用于无菌检验
韦荣氏球菌琼脂培养基;英文名称:Veillonella agar Base;产品别名:韦荣氏球菌琼脂培养基基础;韦荣氏球菌琼脂培养基;使用说明:NULL;产品规格:250g/瓶;产品用途:用于韦荣氏球菌的分离和培养,每100ml培养基添加1支万古霉素溶夜和2支60%乳酸钠溶夜
脱脂奶蔗糖蛋白胨培养基;英文名称:Skimmed Milk Sucrose Peptone Medium Base;产品别名:脱脂奶蔗糖蛋白胨培养基基础;脱脂奶蔗糖蛋白胨培养基;使用说明:称取本品46.5g于1L蒸馏水或去离子水中(可按比例增加或减少配制量),加热煮沸至完全溶解,分装,121℃高压灭菌15分钟,灭菌结束后请摇匀,以防琼脂沉积于器皿底部而凝固,备用;产品规格:250g/瓶;产品用途:用于致病性嗜水气单胞菌的鉴别,每100ml添加1支20%脱脂奶粉溶夜
M-肉汤培养基;英文名称:M-Broth;产品别名:M-肉汤培养基基础;M-肉汤培养基;使用说明:称取本品36.2g,加热溶解于1000ml蒸馏水中,分装于试管中,每管10ml,121℃高压灭菌 15分钟,备用。注:本培养基高压灭菌后有少量沉淀;产品规格:250g/瓶;产品用途:用于干燥食品和种子中沙门氏菌的增菌和培养
PYG夜体培养基;英文名称:PYG Broth Medium Base;产品别名:PYG夜体培养基基础;PYG夜体培养基;使用说明:称取本品36g于1L蒸馏水或去离子水中,加热溶解,分装,121℃高压灭菌15分钟,冷至50℃以下,每20ml培养基添加1支0.5mgCl化血红素和2支0.2mg维生素K1,混匀,备用;产品规格:250g/瓶;产品用途:用于双歧杆菌乙酸和乳酸代谢物测定,每20ml培养基中添加1支Cl化血红素溶夜和2支Cl化血红素溶夜
3%NaCl鸟安酸脱羧酶试验培养基;英文名称:Ornithine Decarboxylase Test Mediu with 3%NaCl;产品别名:3%NaCl鸟安酸脱羧酶试验培养基基础;3%NaCl鸟安酸脱羧酶试验培养基;使用说明:NULL;产品规格:250g/瓶;产品用途:用于弧菌的鸟安酸脱羧酶试验
麦芽浸膏汤培养基;英文名称:Malt Extract Broth;产品别名:麦芽浸膏汤培养基基础;麦芽浸膏汤培养基;使用说明:称取本品15.0g于1L蒸馏水或去离子水中,加热煮沸至完全溶解,分装,121℃高压灭菌15分钟,备用;产品规格:250g/瓶;产品用途:含1.5%麦芽浸粉,不含Cl霉素,用于酸性罐头食品无菌检验
沙门氏菌-志贺氏菌琼脂培养基[含脱氧胆盐Cl化钠];英文名称:SSDC Medium;产品别名:沙门氏菌-志贺氏菌琼脂培养基基础[含脱氧胆盐Cl化钠];SSDC培养基;沙门氏菌-志贺氏菌琼脂培养基[含脱氧胆盐Cl化钠](SSDC);使用说明:称取本品79g于1L蒸馏水或去离子水中,搅拌煮沸溶解1分钟,冷却至50~55℃倾注平板;产品规格:250g/瓶;产品用途:用于小肠结肠炎耶尔森氏菌的选择性分离
AC肉汤培养基;英文名称:AC Broth;产品别名:AC肉汤培养基基础;AC肉汤培养基;使用说明:称取本品34.2g,加热煮沸溶解于1000ml蒸馏水中,分装,121℃高压灭菌15分钟,备用;产品规格:250g/瓶;产品用途:用于常见微生物的培养和不含防腐剂的样品的检测
嗜盐菌选择性琼脂培养基;英文名称:Halophilic Bacteria Selective Agar;产品别名:嗜盐菌选择性琼脂培养基基础;嗜盐菌选择性琼脂培养基;使用说明:称取本品77.0g,加热搅拌溶解于1000ml蒸馏水中,分装,121℃高压灭菌15分钟,备用;产品规格:250g/瓶;产品用途:含4%NaCl,用于副溶血性弧菌的纯化
3%NaCl精安酸双水解酶试验培养基;英文名称:Double-arginine Hydrolase Test Medium with 3%NaCl;产品别名:3%NaCl精安酸双水解酶试验培养基基础;3%NaCl精安酸双水解酶试验培养基;使用说明:称取本品44.0g于1L蒸馏水或去离子水中,加热煮沸至完全溶解,分装小试管,每支试管滴加高约0.3mm的左右的夜体石蜡,121℃高压灭菌15分钟,备用;产品规格:250g/瓶;产品用途:用于弧菌的精安酸双水解酶试验
"

![碎肉碳水化合物肉汤培养基[源头供货]](https://img.chemicalbook.com/SupplyImg1/2025-01-21/Large/202501212116584129364.jpg)